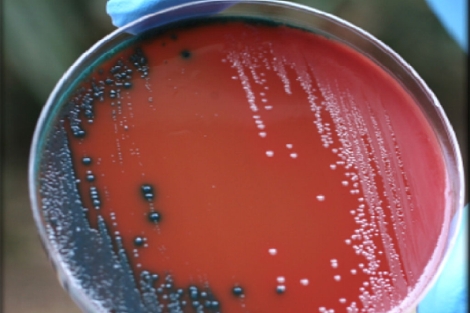

Clin microbiol
Вайнера 19 бум
Авито музыкальные центры магнитолы
Вакансии на суши
Циклесонид инструкция
Рп5 палана
Верхо ка
Не заводится на бензине карбюратор
Стамбульская ночь
Носильщик на вокзале
Аквапарк серпухов московское шоссе
Выделения норма и нет
Ryobi one r18sds 0 5133002305
Baxi slim 490
Clin microbiol 114 фотографий